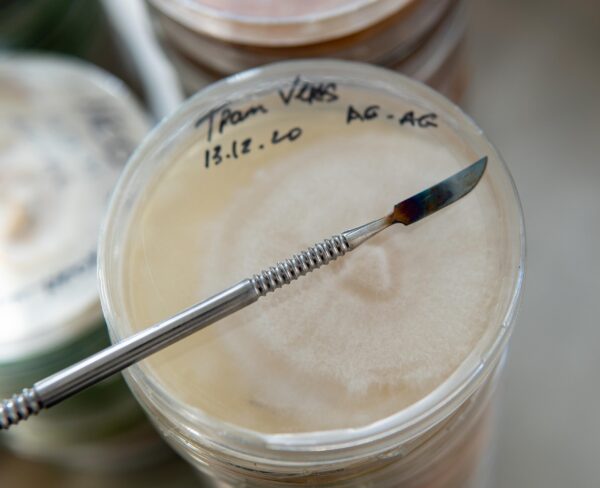
Medio MEA para hongos y bacterias
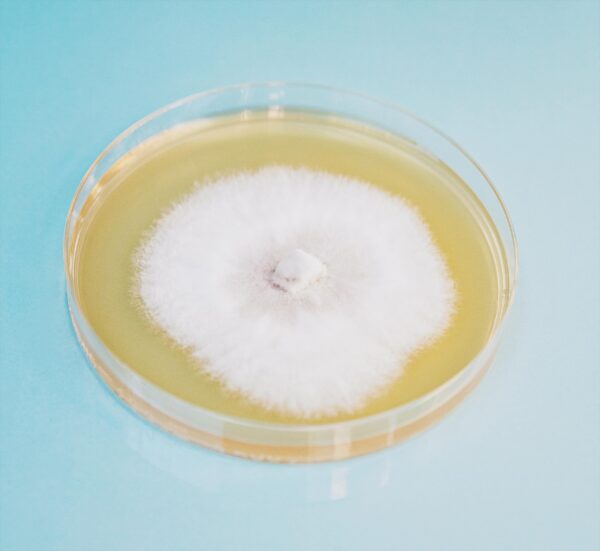
Root Mushroom Farm Agar Extracto de Malta
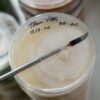
Medio MEA para hongos y bacterias
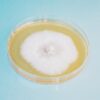
Root Mushroom Farm Agar Extracto de Malta

Marca: Root Mushroom Farm
Tamaño: 1 Contenido (Paquete de 1)
UPC: 850047062215
EAN: 0850047062215
- Proporción premezclada perfecta para hongos, hongos y bacterias.
- Sirve para múltiples propósitos en el cultivo de hongos, incluyendo clonar especímenes comprados o recolectados, expandir cultivos existentes, estriar esporas recolectadas de impresiones de esporas y evaluar la calidad del cultivo líquido.
- El uso recomendado es de 26 gramos de medio por 500ml de agua destilada.
- El producto es suficiente para llenar aproximadamente 140 placas de Petri de tamaño 60mm x 15mm.
El Agar Extracto de Malta (MEA) es un medio versátil utilizado para cultivar varios microorganismos, incluyendo hongos y bacterias. El agar sirve para múltiples propósitos en el cultivo de hongos, incluyendo clonar especímenes comprados o recolectados, expandir cultivos existentes, estriar esporas recolectadas de impresiones de esporas y evaluar la calidad del cultivo líquido. El Agar Extracto de Malta (MEA) es un medio popular para nutrir esporas y cultivos de hongos. Nuestro MEA incluye Extracto de Malta, peptona de soja y Dextrosa. Es una fórmula deshidratada premezclada donde se sugieren 26 gramos de medio por cada 500 ml de agua destilada. La esterilización exitosa requiere 15 PSI durante 30 minutos, seguido de enfriar el medio a 55°C (131°F) antes de verter.

Valoraciones
No hay valoraciones aún.